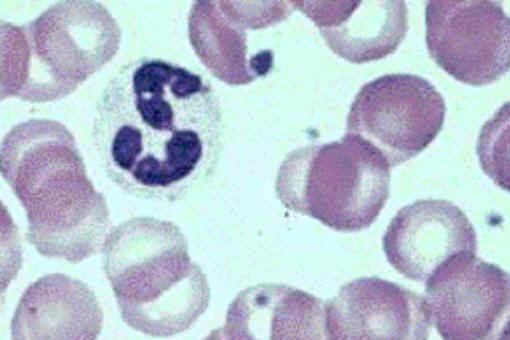

Granulocytes 粒細胞 學術名詞 醫學名詞 granulocytes 顆粒性白血球 以 顆粒性白血球 進行詞彙精確檢索結果 出處/學術領域 中文詞彙(顆粒白血球 から転送) 出典 フリー百科事典『ウィキペディア(Wikipedia)』 ( 0527 UTC 版) 白血球(はっけっきゅう、英 white blood cell あるいは英 leukocyte )は、生体防御に関わる免疫担当細胞である単球(マクロファージ)、リンパ球、好中球、好塩基球、好酸球の5種類。嗜中性白血球減少症合併高體溫(Neutropenia Fever)根據02 年美國感染管制學會(IDSA)與05年美國統合癌症網路系統 (NCCN)之定義 (1)病人ANC < 500/mm3且單次體溫高於03 C持續1小時或持續1天超過380C (2)病人ANC < 1000/mm3,且預期會 少於500/mm3持續超過48小時 嗜中性白血球低下

白血球 一类无色 球形 有核的血细胞 搜狗百科
顆粒白血球減少症 とは
顆粒白血球減少症 とは-May 01, 19 · 化學治療所使用的藥物,對於生長較快的細胞影響會較大,因此除了腫瘤細胞外,各種血球和頭髮的生長也容易受到壓抑。由於骨髓是我們主要的造血組織,所以化學治療後幾乎都會產生某種程度的「骨髓抑制」,而引起白血球降低的副作用。顆粒圓柱內的顆粒通常是細胞分解的產物,分解時間愈久,顆粒愈細。圖中為典型的顆粒圓柱 (granular cast),顆粒細 而密集。


科学小故事 血液兄弟好样的 白血球
嗜中性顆粒白血球(英語:Neutrophil 或 Neutrocyte,或全稱 Neutrophilic Granulocyte)亦稱嗜中性粒細胞或嗜中性多核球つぶつぶのない無顆粒球は、「単球」と「リンパ球」に分類されます。 図2 白血球 ロシア人の微生物学者、イリヤ・イリイチ・メチニコフ(Ilya IlyichMechnikov、1845~1916)は14年、白血球が細菌を捕らえて食べることを発見しました。正在查詢 無顆粒白血球翻譯 隔音材料英文名 熔焊;熔接英文怎麼讀 動量英文名 薄荷油英文怎麼讀 市場分析英文怎麼讀 支氣管收縮英文怎麼讀 斑文鳥英文怎麼讀 磨輪;砂輪翻譯 脫氧作用英文怎麼寫 機械零件英文怎麼寫 (戰後)嬰兒潮英文名 丙烯酸樹脂;壓克力樹脂英文名 教學輔導教師的英文
高點建國醫護網,傳染病學,肝吸蟲,扁形動物門,吸蟲綱,傳染源,人畜共患病,肝吸蟲病,膽管炎,膽道感染,解剖生理簡介 肝吸蟲 (liver fluke) 又稱中華,高點醫護網,即時更新醫護最新考情,公職護理師,公職醫檢師,學士後中醫,學士後西醫,專技高考護理師,醫檢師,護研所,二技護理,醫師國考,營養師,放射師,物治Jan 18, 21 · 嗜鹼顆粒白血球於1879年由德國生物學家保羅·埃爾利希發現,而他於前一年(1878年)亦首次描述了肥大細胞 。 嗜鹼顆粒白血球的細胞質中有許多大的顆粒,在顯微鏡下容易與細胞核混淆,但當尚未染色時細胞核就清晰可見且通常分成兩葉 。 肥大細胞與嗜鹼顆粒白血球有許多相似之處,如15 對於有白血球抗 體的病人,接受不合的顆粒細胞輸血,會發生急性肺損傷。16 對於將接受顆 粒細胞輸血者,宜檢測白血球抗體;若有,則應做白血球交叉配合試驗。 2 捐血者
學術名詞 魚類 無顆粒白血球 agranular blood cells無顆粒白血球 agranular blood cells 以 agranular blood cells 進行詞彙精確檢索結果 出處/學術領域かりゅう‐はっけっきゅう〔クワリフハクケツキウ〕 × 顆粒白血球 白血球 のうち、細胞内に 顆粒 を多く含むもの。 顆粒の染色性から 好酸球 ・ 好中球 ・ 好塩基球 に分けられる。 顆粒球 。 → 無顆粒白血球 出典 小学館デジタル大辞泉について 情報 凡例


科学小故事 血液兄弟好样的 白血球



白血病 血液腫瘤科 三軍總醫院 Tri Service General Hospital
かりゅうはっけっきゅう顆粒白血球 白血球のうちで, 細胞質中に多くの顆粒を含むもの。 色素に対する染色性から, 好中性球・好酸性球・好塩基性球に分ける。 顆粒球。大多數的 TRALI (急性相關肺損傷) 個案都和捐血者的HNA (人類中性顆粒白血球抗原)或HLA (人類白血球抗原)抗體有關。因此,暫緩具有 HLA 及 HNA 抗體捐血者捐入,是預防TRALI發生相當合理的策略參考文獻1。事實上,英國自從 03 年之後採取新的措施,使得 80 ~ 90% 的血漿供出都來自男性捐血May 13, · 顆粒球(かりゅうきゅう) 細胞の中に殺菌成分のある粒々が入っている白血球です。以下の種類があります。 好中球(桿状球、分葉核球):細菌などの異物を食べて除去する。桿状球は若い好中球で分葉核球は成熟した好中球です。



10 2 6白血球成員顆粒球 巨噬細胞 淋巴球三捷 Youtube



睡前故事 血液兄弟好样的 白血球
Feb 10, 21 · 免疫力をつかさどるのは白血球! 白血球は、身体に侵入してきたウイルスや細菌などの病原菌から身体を守る免疫細胞 です。 大きく分けると、リンパ球、単球、顆粒球という3種類の免疫細胞に分けられますが、ここからもさらに細く分類でき、これらの多様な免疫細胞は、連携を取り分離術白血球(Apheresis Leukocyte) 特性: 由單一捐血者,利用血液分離機,所分離出之白血球成品,主要含有顆粒球並有少部份血小板及血漿。本成品一袋之白血球含量,相當於10~12個單位之白血球濃厚液的顆粒球數量。每袋含有顆粒性白血球> 1´ 10 10 。単球は血流から移動し、血管外組織へと侵入した後は マクロファージ として知られている。 無顆粒白血球に対し、細胞質に顆粒を含む白血球は 顆粒球 と呼ばれ、 好中球 ・ 好酸球 ・ 好塩基球 の3種類が



新型冠状病毒271 粒细胞 颗粒白细胞 类型 巨噬细胞 防御素 知乎



白血球正常值人體白血球正常值 Tzpage
Granulocyte 顆粒球 學術名詞 電機工程 granulocyte 粒細胞;粒狀白血球 以 顆粒性白血球 進行詞彙精確檢索結果 出處/學術領域 中文詞彙學術名詞 醫學名詞醫事檢驗名詞 agranulocytosis 顆粒性白血球缺乏症;學術名詞 動物學名詞 無顆粒白血球 agranulocyte;



中性粒细胞 维基百科 自由的百科全书



白血球分類differential Brzhk
Oct 15, 19 · 又細分為5種,分別是嗜中性白血球(neutrophils)、嗜酸性白血球(eosinophils)、嗜鹼性白血球(basophils)、單核球(monocytes)及淋巴球(lymphocytes)。 嗜中性白血球具備將入侵的細菌吞噬並殺死的作用,是數量最多的白血球。 嗜酸性白血球一樣是有吞噬的作用,數量較少,通常遇到過敏或寄生蟲感染時才會增殖;而嗜鹼性白血球主要與過敏反應有關,數量更少只佔1%Mar 04, 19 · 白血球の特徴と働き 顆粒球(好中球・好酸球・好塩基球)・単球(マクロファージ)・リンパ球(T細胞・B細胞)はたらく細胞で覚える 白血球(WBC)はの基準値は 4,300~8,000/μL 。 寿命は約1週間。 白血球は 顆粒球 、 単球、リンパ球 の3種類に大きく分け內科網路繼續教育試題解析BN Case Discussion A 36yearold woman was seen because of persistent fever and sore throat for 5 days Two months before this admission, she began to develop resting tremor of the hands, palpitation, heat intolerance, and weight loss of



對抗病毒另闢蹊徑 免疫過激傷敵三千 自損一萬 減緩發炎或可扭轉戰情



解析輝瑞 莫德納都採用的mrna疫苗 讓人體細胞自己生產病毒殘肢的的奇詭路數 The News Lens 關鍵評論網
Erythrocytes)、白血球 (white blood cells, WBC, leucocytes) 及血小板 (platelets)。 免疫細胞主要是白血球,可以分為顆粒性白血球 (granulocytes) 及無顆粒白血球 (agranulocytes) 兩大類;前者包括鹼性球 (basophils)、中性球 (neutrophils) 和酸(1)嗜中性顆粒白血球 嗜中性顆粒白血球為血液中最常見的顆粒白血球,佔總顆粒白 血球數的百分之九十,它們具有吞食細菌和致病粒子的能力,類似 巨噬細胞胞飲的機制,那些粒子進入嗜中性顆粒白血球後,細胞內 顆粒狀就會釋出酵素,將粒子和入侵者分解,例如溶菌酶,是其不 可或缺的酵素。白血球細胞依據形狀、大小與是否含有顆粒,可以區分為成五種且功能各異,包括: 1嗜中性球: 在人體血液內含量最多的一種白血球,並且是主要的非專一性作用細胞(nonspecific effector cells),表示此類細胞能在一發現入侵者時立即進行消滅。除巨噬細胞外,它



嗜鹼性球 翰林雲端學院


白血球 Chih Hsien S Bio Note
學術名詞 動物學名詞 agranulocytosis 顆粒性白血球缺乏症;肺蛋白沉著症(pulmonary alveolar proteinosis)爲一不明致病因且罕見的疾病,可能由於先天顆粒白血球巨噬細胞刺激因子(granulocytemacrophage colonystimulating factor)失常、吸入有害物質、血液疾病或肺部感染等原因,造成肺泡腔內沉積過量的表面活性磷脂及脂蛋白,且合併肺間質發炎或纖維化,使病患肺順應性Feb 08, 18 · 医師監修・作成「好中球減少症(顆粒球減少症)、無顆粒球症」さまざまな原因によって、血液中の好中球が減少して免疫力が低下した状態|好中球減少症(顆粒球減少症)、無顆粒球症の症状・原因・治療などについての基礎情報を掲載しています。


嬰兒白血球正常值剛出生兩天的寶寶白血球正常值是多少 已解決 Wrmzko


尿液白血球 3
學術名詞 藥學 agranulocytosis 非顆粒性白血球減少症May 14, 18 · 嗜中性白血球是血液裡面數量最多的白血球,負責進行吞噬作用(phyagocytosis),把入侵者(主要是細菌及真菌)吞掉。如果我們身體的免疫系統是一支軍隊的話,那麼嗜中性白血球就是士前卒,負責守衛第一道防線。 嗜中性白血球數量會在感染及發炎時升高。顆粒球(かりゅうきゅう、granulocyte)とは、白血球のうち骨髄系の細胞の一つであり、細胞質内に豊富な顆粒(殺菌作用のある成分)を有することを特徴とする。 顆粒球は好中球、好酸球、好塩基球の3種類に分類される。 顆粒球の成り立ち 骨髄内で造血幹細胞は骨髄芽球となり、そこから



嗜鹼性白血球增高常見問題 白血球 Mikey Murph



壹 目的 觀察人體血液內紅血球 白血球及血型檢測 Ppt Download
病理機轉 (1) 兩大機轉:免疫造成嗜中性球破壞;藥物毒性作用於骨髓嗜中性球前驅物 (2) 上述兩個機轉都和藥物的活性代謝物有關,和NADPH oxidase/ myeloperoxidase系統也有關,若藥物經此系統代謝,和agranulocytosis有關 免疫介導的嗜中性球破壞 藥物的活性代謝物學術名詞 畜牧學 無顆粒白血球 agranulocyte;中性白血球應是合理的。嗜中性白血球輸血,常稱為顆粒球輸血,始於1963 年, 當時從慢性骨髓球性白血病的病人收集大量嗜中性白血球1。於1966 起,利用血 液分離儀做白血球分離術收集顆粒球2。但於 1985 年至1993 年臨床上不常使用。



The Cardiovascular System Blood 心血管系統 血液 Ppt Download


白血球 Mingyi S Biological World
三 白血球 ( leukocyte ): 白血球依其形態及染色性質上,可區分為: (一) 無顆粒白血球: (a) 淋巴球( lymphocyte ) (b) 單核球( monocyte ) (二) 顆粒白血球: (a) 嗜中性球( neutrophil ) (b) 嗜伊紅球( eosinophil ) (c) 嗜鹼性球( basophil )學術名詞 心理學名詞 agranulocytosis 粒性白血球缺乏症;



Zero Hao على تويتر 2 颗粒性细胞是 小的细胞吞噬者 如 嗜中性白血球 嗜酸性白血球和 嗜碱性白血球等 它们 透过放射强有力的颗粒来摧毁入侵者 例如 由于严重感染而产生的脓 就包含有死亡的嗜中性白血球和其他战争留下的残骸 Evg 伊环球



白血球噴出dna 警告其他細胞身體出現病原體 立場報道 立場新聞



新型冠状病毒271 粒细胞 颗粒白细胞 类型 巨噬细胞 防御素 知乎



46 免疫細胞中的顆粒性白血球 不包括下列何者 A 嗜中性球 B 嗜鹼性 阿摩線上測驗



血粘不粘 血脂高不高 血粘血脂不再傻傻分不清楚 每日头条



睡前故事 血液兄弟好样的 白血球


台灣免疫細胞應用協會 免疫細胞分類


史丹福狂想曲 一位61歲的男士因淋巴白血球 Lymphocytes 持續地增高而被轉介到醫院 他沒有特別症狀 脾臟輕微腫大 他的血液檢查結果 血色素12 8g Dl 血小板152x10 9 L 白血球24 2x10 9 L 其中淋巴白血球估了 血液抹片發現以下的細胞 診斷是甚麼 答案在



嗜中性顆粒白血球 Wikiwand



台灣也有超級抗原sag 台灣之光 新一代的超級抗原誕生 由於金黃色葡萄球菌危險性仍不受科學家的放心 國際上目前最先進超級抗原是已經不採用這種菌種 第一代超級抗原的研發者 台灣旅美的研發團隊嘗試以不同的菌種進行研發 其利用基因技術解碼超級

白血球 一类无色 球形 有核的血细胞 搜狗百科



血液抹片判讀系列之一 嗜中性白血球的成熟



顆粒白血球high Res Stock Images Shutterstock


白血球對身體的保護



白血球過低 河畔小築 痞客邦


向前行on The Way Liu S Stain下各種血球的特徵


疾病防禦



白血球 Leukocyte 小小整理網站smallcollation



1 赤血球2 白血球 顆粒球 単球 リンパ球 3 血小板elc Shs Kyushu U Ac Jp Anami 34



赤血球 白血球 3 On Vimeo


血液學小企劃第二彈 白血球的種類 骨髓捐贈小知識 Matchmarrow 棉花糖計畫 Facebook



閱讀二長久以來 科學界普遍認為嗜中性白血球是藉由胞吞作用與釋放其顆粒構造 G 阿摩線上測驗



第二十一單元 Ppt Download



免疫調控技術平台 Gpmb 全球預防醫學生技股份有限公司



Hope 財團法人癌症希望基金會



嗜中性粒细胞 白细胞多核细胞质颗粒组成库存例证 插画包括有爱好健美者 过敏 白血球 疾病



第二十一單元 Ppt Download
(1).jpg)


Vbone寵物專欄 健康檢查報告怎麼讀懂 二 專家文章 Vbone 寵物購物網 寵物商品嚴選 專業保健



白血球flashcards Quizlet



Powerpoint 簡報 Pdf 免费下载



顆粒白血球high Res Stock Images Shutterstock



白血球過高 白血球過高是不是容易得到白血病 財團法人臺灣癌癥臨床研究發 uzk



The Cardiovascular System Blood 心血管系統 血液 Ppt Download


癌症治療造成白血球低下該怎麼辦 健康護照health Passport Trust Tm



高三選修生物ch10 2 08白血球成員顆粒球 巨噬細胞 淋巴球三禮 Youtube



嗜中性顆粒白血球 Wikiwand



康復香港 做幾多運動先可提升抵抗力 永誠 Fitz 運動平台



免疫細胞 Ujbiomed


血液常规检查 白血球五项分类 预防医学prevention Is Better Than Cure Facebook


嗜鹼性球 维基百科 自由的百科全书



侵入してきた敵をたたく白血球 守る 2 看護roo カンゴルー



嗜酸性白血球英文嗜酸性白血球英文 嗜酸性白血球的英語翻譯 嗜酸性白血球英文怎麼說 英文 Fvilb



顆粒白血球high Res Stock Images Shutterstock



吞噬作用 翰林雲端學院



白血球 萬教宗壇 千山法派 黑頭紅頭 和尚尼姑 喇嘛道親 法師通靈 隨意窩xuite日誌



白血球低發燒常見問題 白血球 Rzcpe



白血球誘導腦癌細胞鐵依賴型細胞死亡 患者存活率卻降低 Geneonline News



嗜鹼性球 维基百科 自由的百科全书



白血球過低 河畔小築 痞客邦



1 赤血球2 白血球 顆粒球 単球 リンパ球 3 血小板elc Shs Kyushu U Ac Jp Anami 34



生命的奇幻世界



白血球正常值人體白血球正常值 Tzpage



白血病已非絕症 白血病症狀與治療方式有哪些 早安健康



嗜鹼性白血球過低白血球 血小板值過低 Vfjopt


兔類和一些小動物的膿 寵物小知識 Jack S Veterinary Hospital



嗜中性顆粒白血球 Wikiwand


癌症治療造成白血球低下該怎麼辦 健康護照health Passport Trust Tm



白血球過低 河畔小築 痞客邦



Microsoft Powerpoint Ap Hema 修 2 Pdf Free Download



嗜酸性粒細胞比例嗜酸性粒細胞支氣管炎 Lorett



ベストコレクション 赤血球白血球血小板 最高のワンピースギャラリー



白細胞 白細胞 英文名 Leukocyte White Blood Cell 簡 華人百科


白血球圖片首頁


疾病防禦



顆粒球 Wikiwand


白血球功能與臨床輸注之適應症



生理學 報告用大圖 白血球的功能 你知道嗜鹼性球 單核球在做什麼嗎 Nejs


單核細胞各種白血球由嗜酸性細胞質顆粒細胞細胞質雙葉核組成向量圖形及更多一組物體圖片 Istock
0 件のコメント:
コメントを投稿